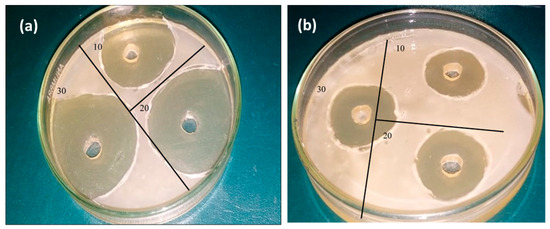

Abstract
The present study demonstrates the synthesis of phase pure hematite (α-Fe2O3) nanoparticles (NPs) using collagen protein and calcium carbonate extracted from eggshell membranes and eggshells, respectively, as organic additives. To test the influence of organic additives on the quality of the resulting NPs, the amount of eggshell powder was varied between 1 to 5 g in aqueous iron nitrate solution. X-ray diffraction (XRD), Fourier transform infrared spectroscopy (FTIR), and RAMAN analysis confirmed the formation of hematite NPs without any impurities. FTIR spectra revealed the presence of polyphenolic constituents on the surface of the resulting NPs as stabilizers, which may potentially be responsible for the observed antioxidant and antibacterial properties. Furthermore, the stable phase and the presence of low defects divulged the high hardness value (~983 HV) and fracture toughness (8.59 MPa m1/2), which can be exploited for bone implantation. The FE-SEM results demonstrate the formation of spherical particles, which are well-separated NPs. The results of a biodegradation study which was carried out in phosphate-buffered saline (PBS) revealed that the as-prepared NPs retained their hardness even after 72 h of soaking. These prepared NPs showed 95% radical scavenging activity (RSA) and were good carriers against S. aureus bacteria. Moreover, the SEM images of the mineralization of iron oxide NPs confirmed the formation of new bone. After 5 weeks, all pores were filled, and the minerals were deposited on the surfaces of the scaffolds.
1. Introduction
Nanotechnology has emerged as a revolutionary field of science, with vast applications ranging from electronics and energy to medicine and environmental protection. The unique properties exhibited by nanomaterials have garnered tremendous attention, making them the focus of extensive research [1]. Among the diverse array of nanomaterials, metal oxide nanoparticles (NPs) have emerged as a promising candidate for potential applications in various fields owing to their distinctive physicochemical properties at the nanoscale, which often differ significantly from their bulk counterparts [2]. These properties are mainly attributed to the high surface-to-volume ratio, leading to enhanced surface reactivity, and quantum confinement effects resulting from the confinement of electrons within the nanoparticle’s structure. As a consequence, metal oxide NPs exhibit unique electrical, optical, magnetic, and catalytic properties. Some of the most extensively studied metal oxide NPs include, but are not limited to, zinc oxide (ZnO), titanium dioxide (TiO2), iron oxide (Fe2O3), copper oxide (CuO), cerium oxide (CeO2), etc. [3].
Among various metal oxide NPs, Fe2O3 is very fascinating and holds immense promise as a multifunctional nanomaterial. The significance of Fe2O3 NPs stems from their exceptional attributes, such as high surface area, excellent stability, and catalytic activity, making them ideal for a wide range of applications. Fe2O3 exists in different phases, such as α-Fe2O3 (hematite), γ-Fe2O3 (maghemite), β-Fe2O3, and ε-Fe2O3 [4]. α-Fe2O3 (hematite) is extremely stable, abundant, inexpensive, environmentally sustainable, less toxic, biodegradable, and biocompatible. It has a narrow band gap and exhibits strong absorption in the visible and near-infrared regions. This particular phase demonstrates enhanced performance in biological, environmental, and various technological applications [5].
The properties, and, hence, the applications, of synthesized nanoparticles could be strongly controlled by a particular synthesis process. α-Fe2O3 NPs have been synthesized using various routes, such as hydrothermal, solvothermal, and co-precipitation methods; vapor–solid growth techniques; the sol–gel method; laser ablation; the template-assisted method, etc. [6,7,8,9]. The sol–gel synthesis method has several advantages, such as excellent control over microstructures, nanoparticle sizes, shapes, variation in material properties by the composition of the precursor, and low processing temperature [10]. However, even the sol–gel synthesis method, like most of the other methods mentioned above, often involves the utilization of toxic and expensive chemical reducing and stabilizing agents for the synthesis of α-Fe2O3 NPs with controlled sizes and stability [11].
In recent years, the importance of green synthesis techniques has become increasingly evident due to their eco-friendly nature and minimal adverse impact on the environment. Green synthesis techniques utilize naturally occurring reducing and stabilizing agents such as plant extracts, microorganisms, etc.
In this context, eggshell-based green synthesis of NPs has gained attention for its sustainable approach and cost-effectiveness. Similar to other natural materials, eggshells contain natural antioxidants, such as flavonoids and phenolic compounds, which can potentially act as reducing agents during the green synthesis of NPs [12]. Moreover, the presence of calcium carbonate, proteins, and polysaccharides in eggshells may also contribute to the stabilization and control of NP growth. Hence, eggshells offer an abundant, biocompatible, and biodegradable precursor for the synthesis of NPs [13]. Bone regeneration is typically used when a bone needs to heal. Until now, a wide variety of scaffolds have been used, e.g., collagen, but they cause rapid absorption and have low hardness, in addition to the costs. Thus, here, naturally available eggshells and membranes are used for enhancing the physical properties and bioactivity of iron oxide. The scaffold exhibited adequate flexibility and mechanical strength as a biomedical platform for bone regeneration. The dispersed NPs were found to regulate and enhance cell morphology, mineralization, and adhesion and to decrease degradation in vitro. The presence of eggshells and membrane-added NPs have gained potential interest in scaffold and tissue engineering. The presence of eggshells and membranes especially increased the interaction between the cells and the scaffolds. The eggshells and membranes also provided constituent elements, which are necessary for bone regeneration [14].
Several reports could be found on the green-synthesized α-Fe2O3 NPs using naturally occurring resources. These nanoparticles hold immense importance in various applications, as their eco-friendly production method ensures minimal environmental impact while retaining their exceptional properties, making them ideal candidates for sustainable and biocompatible solutions in medicine, environmental remediation, and energy storage. Considering the broad range of potential applications of α-Fe2O3 NPs, researchers are continuously exploring their multifunctional properties.
For instance, the antibacterial activity of α-Fe2O3 NPs, which were prepared using the green synthesis method, was tested against E. Coli and Bacillus subtilis bacteria. The synthesized NPs were found to be more efficient against Bacillus subtilis as compared to E. Coli, with observed zone of inhibition (ZOI) values of 16.00 and 11.33 mm, respectively [15]. Another report was found on the antibacterial activity of iron oxide nanoparticles prepared via the microwave method using hibiscus flower extract as a reducing and stabilizing agent. The reported ZOI value was 5 mm [16]. Mesoporous α-Fe2O3 NPs using green tea extract showed photocatalytic activity two times higher than that of commercial ones [7]. Rhus punjabensis extract was used as both reducing and capping agent for the phytomediated synthesis of hematite NPs from a ferric chloride precursor. NPs exhibited cytotoxic effects against HL-60 leukemic and DU-145 prostate cancer cell lines, with ED50 values of 11.9 and 12.79 μg/mL, respectively [5]. Piper betel leaf extract was used to synthesize α-Fe2O3 NPs from anhydrous ferric chloride. The nanoparticles showed enhanced antibacterial activity against Pseudomonas aeruginosa and Streptococcus mutans, and also showed anticancer potential against A549 (lung cancer) cells [17]. α-Fe2O3 NPs synthesized using Vernonia amygdalina (V. amygdalina) leaf extract and Fe(NO3)3.9H2O precursor were reported to effectively degrade methylene blue and methylene orange dyes [18]. Various extracts have been used to synthesize α-Fe2O3 NPs using the green synthesis approach; however, to the best of our knowledge, no report has been made on the eggshell-based green synthesis of α-Fe2O3 nanoparticles for a simultaneous antibacterial, antioxidant, and mineralization study.
The current study aims to explore the fascinating applications of α-Fe2O3 NPs. Morphological, structural, compositional, and mechanical analyses were performed using SEM, XRD, FTIR, RAMAN, and a hardness Vickers indenter, respectively. Our research encompasses an in-depth investigation of the antibacterial potential, antioxidant efficacy, and mineralization capabilities of these NPs. The findings of this study show the novel synthesis of hematite, and eggshells play an important role in the generation of well-defined, non-agglomerated, spherical NPs with enhanced antioxidant properties as compared to the previous literature [19]. Eggshell-mediated hematite NPs demonstrate the formation of hydroxyapatite. Very few reports are available on the use of hematite as a scaffold with reasonable hardness [20].
2. Materials and Methods
2.1. Materials
Iron nitrate nonahydrate, Fe(NO3)3, 9H2O (Sigma Aldrich, St. Louis, MO 63118, USA), and de-ionized (DI) water were used as the starting materials. Eggshells were used as an organic additive.
2.2. Preparation of Eggshell Powder
Hen eggshells with the membrane were separated from the egg white and yolk. Eggshells were washed with DI water thoroughly and dried in an oven at 50 °C. Dried eggshells were ground to form a fine powder [21].
2.3. Preparation of Eggshell Additive Iron Oxide
A sample of 4.04 g of iron nitrate was dissolved in 500 mL DI water to form a stock solution with a molarity of 0.1 M. This stock solution was stirred at room temperature. pH was measured as neutral. Iron nitrate reacted with DI water and formed iron hydroxide as shown in Equation (1):
Next, 1, 2, 3, 4, and 5 g of eggshell powder were added per 100 mL mixture of iron nitrate. During the synthesis, eggshells were attached to iron. The above mixture was stirred at room temperature until its color changed from yellow to rust orange. The pH was measured as neutral. Then, the mixture was dried at 60 °C, washed with DI water, and centrifuged three times to remove by-products [22]. Figure 1 shows a schematic representation of iron oxide NPs.

Figure 1.
Schematic representation of eggshell-mediated iron oxide NPs.
2.4. Characterizations
Iron oxide NPs were examined using an X-ray diffractometer (Rigaku, Japan) at various eggshell amounts. The scanning range was 20 to 70°, with 0.05° intervals. Using a confocal Raman spectrometer (Renishaw inVia, UK, Argon laser wavelength = 514 nm), a further phase confirmation was carried out. FE-SEM (Nova Nano SEM 450, USA) was used to evaluate the morphology at various magnifications. The Vickers nano-indenter was first to be used to examine the models’ toughness in order to conduct an analysis. The functional groups were investigated using the FTIR Bruker Tensor II (Bruker, Germany). Additionally, a spectrum with a resolution of 4 cm−1 was acquired in the 600–2000 cm−1 region using a Rock Solid Interferometer.
2.4.1. Biodegradation Study
Iron oxide, with eggshells, was subjected to a degradation study in phosphate-buffered saline (PBS), with lysozyme as the primary component. The primary enzyme responsible for scaffold degradation in vivo is lysozyme [23,24]. Eggshell-mediated iron oxide NPs were immersed in 10 mg/L of PBS for different durations: 1, 2, 3, 4, 5, 6, and 7 days. Iron oxide NPs with eggshells were inspected for degradation before and after soaking in PBS. DI water was used to clean the iron oxide NPs, and after soaking, they were separated. Samples were dried for 48 h after separation to remove any remaining water. The formula found in Equation (6) [25] was used to calculate the weight loss of the thoroughly cleaned NPs:
where
- W1 = weight before soaking;
- W2 = weight after soaking.
2.4.2. Antimicrobial Activity Evaluation
To evaluate the antibacterial efficacy of the extracted materials, two strains were used. On Lauria Bertani medium (LB), S. aureus (ATCC23235) and E. Coli (ATCC25922) were sub-cultured and incubated for 24 h at 37 degrees Celsius. The antibacterial activity was evaluated using the disc diffusion method. Using a sterile swab and a saline suspension (NaCl, 0.9 percent), which had previously been calibrated using the 0.5 Mc Farland standard, the investigated strains were uniformly injected into the LB medium. Whattman paper discs measuring 6 mm in diameter were placed over the culture substrate and then submerged in the tested extract [26]. After incubating the inhibitory halos for 24 h at 37 °C, their diameter was measured. Three different doses of 10 mg/mL, 20 mg/mL, and 30 mg/mL were prepared, and the extract was diluted in DMSO.
2.4.3. Antioxidant Study
The study of antioxidants is crucial for biomaterials and implants. The radical scavenging capacity of iron oxide NPs produced with 5 g of eggshell material was examined. Utilizing the DPPH (1, 1, diphenyl-2-picryl hydrazyl) test, the antioxidant capacities of the produced samples were investigated. De-colorization (purple to light yellow) brought on by the neutralization process was the primary mechanism underlying the antioxidant effect. The DPPH and methanol solution received the optimum NP addition. The entire mixture was kept in a dimly lit chamber at 37 °C for 30 min. The data of the absorbance peak at 517 nm and decolorization were used to confirm the measurements. Using Equation (3) [27], the percentage of scavenging activity was calculated:
where ascorbic acid was used as the control.
2.4.4. In Vitro Bio-Mineralization Study
Eggshell-mediated iron oxide scaffolds were soaked in stimulated body fluid (SBF) [28] for 1, 2, 3, 4, and 5 weeks, and then washed with DI water. SEM was used to view the formation of new bone.
3. Results and Discussion
3.1. Structural Analysis
The main purpose of this study is to study the effect of eggshell powder on the structural and mechanical properties of hematite NPs. Mechanical properties are strongly enhanced by the stable phase and high crystallinity of the resulting NPs. Figure 2 depicts the XRD patterns of eggshell-mediated iron oxide aided by the sol–gel method. The peaks correspond (012), (104), (110), (024), (116), and (214) planes of the rhombohedral structure of α-Fe2O3 (JCPDS card no. 33-664) [29]. Samples synthesized with a relatively low eggshell content (1 g) exhibited low crystallinity, as shown in Figure 2a. The intensity of the peaks began to increase at 2 g of eggshell content (Figure 2b) and the phase was strengthened by up to 5 g (Figure 2e). As the eggshell content increased up to 2 g, another plane (116) appeared. Notably, with increasing eggshell content, the phase of iron oxide NPs also strengthened, which was clearly visible with the appearance of the reflection due to the (214) planes, for instance. The main reason for the higher content of organic additives is that it causes rapid heating in sol and results in increased crystallinity.

Figure 2.
XRD pattern of α-Fe2O3 for different eggshell contents: (a) 1 g, (b) 2 g, (c) 3 g, (d) 4 g, and (e) 5 g.
Gaussian fitting was applied for further analysis from XRD data. Numerous parameters, e.g., full width and half maximum (FWHM), exact peak center value, and area IntgP were investigated. For 1 g of eggshell content (Figure 3a), a relatively higher FWHM was observed, and the characteristic peak 2θ = 33.7° was 1.44. A slight shift in characteristic peak 2θ = 33.6° was observed with the eggshell content (2 g) due to stresses generated by the addition of organic content [30], with a FWHM of 0.96. The intensity of the characteristic peak increased along 2θ = 33.70°, with slight increase in FWHM 1.04. In comparison with 2 g of eggshell content, FWHM increased, while compared to 1 g, FWHM decreased. With a further increase in eggshell content up to 5 g, FWHM decreased which confirms the crystallinity of α-Fe2O3. The fitting of XRD data also provided the area IntgP. The areas of characteristic peak for 1, 2, 3, 4, and 5 g of eggshell content were 30.93%, 32.75%, 40.03%, 49.56%, and 58.62%, indicating the strengthening of the hematite phase.

Figure 3.
Corresponding XRD-fitted diagram of eggshell-mediated hematite: (a) 1 g, (b) 2 g, (c) 3 g, (d) 4 g, and (e) 5 g.
The crystallite size was determined using Scherrer’s formula, given in Equation (4) [31]:
where, Dhkl = crystallite size, λ = 1.5406 Å, and δ = dislocation density.
The crystallite size of eggshell-mediated iron oxide is shown in Figure 4. The crystallite size increased up to 2 g of eggshells, while a slight decrease in crystallite size was observed at 3 g. Further increases in eggshell content led to larger crystallite sizes. As observed in Figure 2, a higher shell content led to phase strengthening and stabilization. After reaching phase stability, the emergence of nuclei occurred, resulting in larger crystallites. From the crystallite size, the dislocation density (lines/m2) was also calculated by Equation (5). Almost-decreasing behavior was observed for dislocation density, which is a prerequisite for bone applications. Notably, electrostatic attraction to charged groups, substitution of metal ion ligands by appropriate nucleophilic groups of the protein, or a hydrophobic kind of contact are all possible ways for Fe3+ to bind to the protein [32]. This binding leads to an increase in crystallinity and phase strengthening.

Figure 4.
Crystallite size and dislocation density of eggshell-mediated hematite NPs.
For bone implantation, the unit cell volume and density play important roles. A slight shrinkage in volume was observed with the eggshell content. The unit cell volume of hematite NPs was determined by Equation (6), [31] and is graphically presented in Figure 5.

Figure 5.
Unit cell volume and X-ray density of eggshell-mediated hematite NPs.
In Figure 5, X-ray density is also present. A relatively higher X-ray density (~5.41 g/cm3) was determined in organic additive iron oxide. This calculated X-ray density has also been used for porosity calculations. Equations (7) and (8) are used for density and porosity calculations, respectively [31]. Figure 6 represents the very low porosity with a higher eggshell content.

Figure 6.
Porosity of eggshell-mediated hematite NPs.
3.2. Raman Analysis
A Raman analysis of eggshell-mediated hematite NPs is shown in Figure 7. Usually, seven phonon peaks are present in the Raman spectrum of hematite. In the literature, hematite peaks are found at 225 cm−1 (A1g), 249 cm−1 (Eg), 293 cm−1 (Eg), 297cm−1 (Eg), 410 cm−1 (Eg), 496 cm−1 (Eg), and 608 cm−1 (A1g) [33]. An almost identical spectrum has been observed (Figure 7), as described in the literature. Figure 7 contains six main peaks, and the intensity of the peaks is shown to increase along with the eggshell content, which is in good agreement with XRD results. Hematite NPs usually contains broad peaks in Raman analysis as compared to its other phases [34]. On the other hand, the broadness of the peaks gives an indication of small NPs. Here, we used organic additives, which changed the local environment of the particles, leading to a strong electron–phonon interaction and the enlargement of bandwidths.

Figure 7.
Raman spectra of eggshell-mediated hematite (a) 1 g, (b) 2 g, (c) 3 g, (d) 4 g, and (e) 5 g.
3.3. FTIR analysis
FTIR spectra of iron oxide are presented in Figure 8 for various eggshell contents. Figure 8 reveals that the samples mostly contained carboxyl, phenolic, and hydroxyl groups. The peak at 720 cm−1 belongs to Fe-O stretching. A broad band at 868 cm−1 confirms the presence of phenol groups, and the appearance of a new peak at 840 cm−1 demonstrates that Fe cations interact with C-O [35]. As the eggshell content increased, the phenol group width of this band increased, and sharpness of the band was observed. Eggshells were added aiming for applications in bone implantation. The formation of metal carboxylate due to the presence of minerals on the surface of iron oxide facilitates the formation of new bone. This type of investigation was is also reported by Yang et al. [36]. The strongest one was observed at ~1400 cm−1. Based on the literature [37,38], the band observed at ~1400 cm−1 was assigned to calcium carbonate coming from the eggshells. The intensities of the FT-IR peaks in the region of 1350 cm−1–1650 cm−1 decreased, which may possibly point towards alterations in the calcium carbonate contents. From these results, we can conclude that the eggshells were bound to the surface of the hematite. This reaction may occur during drying to form phenol groups and surface hydroxyl groups. The drying process may promote localized heating production due to the presence of organic additives. A comparison between Figure 8a and 8e indicates that peaks for phenol groups and calcium carbonate were present in all spectra. Therefore, it was concluded that hematite NPs are also modified by eggshells [36,39].

Figure 8.
FTIR patterns of α-Fe2O3 for different eggshell contents: (a) 1 g, (b) 2 g, (c) 3 g (d) 4 g, and (e) 5 g.
3.4. Hardness and Fracture Toughness
The main aim of synthesizing eggshell iron oxide for bone applications means that strength and toughness are very important. A Vickers nano-indenter was utilized to measure the hardness and the fracture toughness of the samples. Hardness was mainly influenced by the density and porosity of the samples. Figure 5 represents that the density of the samples increased with phase strengthening and eggshell content. The same trend was observed when measuring the hardnesses of the samples. The hardness of the samples increased, and a maximum of 983 HV was observed with 5 g of eggshell content. Table 1 represents the mechanical values. Fracture toughness was also calculated using the crack length produced with indentation. Ten measurements were taken to verify the standard JIS R 1607 [40]. Normally, three models are working: (1) Palmqvist cracks, (2) half-penny crack, and (3) curve-fitting. The model selection was based on the c/a ratio, as reported earlier [41]. If c/a < 2, then normally, the Palmqvist model is used [42,43].

Table 1.
Hardness and fracture toughness of eggshell-mediated hematite NPs.
The fracture toughness, KIc (MPa m1/2), was determined using Equation (9) [44]:
where H = hardness (MPa), E = Young’s modulus (210,000 MPa), d = average diagonal line length of the indentation, and c = average length of the Palmqvist cracks.
Table 1 and Figure 9 show the variation in fracture toughness with the eggshell content. The main parameters affecting the values of hardness and fracture toughness were phase purity, grain size, porosity, density, crack-free structures, and agglomeration. Following Equation (10) further confirms the relation between porosity and hardness.
where Ho = hardness of the material, b = constant, and P = porosity.

Figure 9.
Hardness and fracture toughness of eggshell-mediated hematite NPs.
Low porosity and a non-agglomerated structure results in a high hardness value. The formation of a non-agglomerated structure was observed by field emission scanning electron microscopy (FE-SEM).
3.5. Morphological Study
Images from the FE-SEM for 5 g of eggshell content are shown in Figure 10a,b. The images show some porosity and particle agglomeration content. It can be seen that the particle contribution basically remained constant as the eggshell content increased, and the dispersion was good. The synthesis method determined the size of the nanostructures and the phase fraction. With size ranges of 40 to 50 nm, almost spherical NPs were produced. According to XRD calculations (Figure 6), the samples’ porosity declined and reached a minimum value at 5 g of eggshell content. There was still some porosity accessible, which was necessary for the scaffold to create a link with biological tissues. The structural similarity of nucleation sites is a misleading feature regulating the phase composition; there is no conclusive theory that predicts the quantitative crystal structure. Iron nitrate was utilized as a precursor during the synthesis of iron oxide, resulting in a hydro complex whose structure was extremely close to that of hematite [45].

Figure 10.
FE-SEM images of eggshell-mediated hematite NPs for (a) 5 g content (b) magnified view at 5 g.
3.6. In Vitro Biodegradation Study
These phase-pure, dense, and hard hematite NPs were utilized for a biodegradation study in terms of loss in weight and hardness. NPs containing 5 g of eggshell iron oxide were placed in phosphate-buffered saline (PBS) for 1, 2, 3, 4, 5, 6, and 7 days. Variations in hardness and weight were measured after fixed intervals. It is worth mentioning here that synthesized NPs showed slight variation even after 7 days. Although the hardness of the sample decreased gradually, it still had a suitable hardness for bone implantations. The variation in value was calculated by Equation (2) and is summarized in Table 2.

Table 2.
Biodegradation study of egg shell added hematite.
The result demonstrates the steep decrease in weight and hardness with the increase in time immersed in PBS. However, the biocompatibility of eggshell-mediated hematite NPs hindered regular cell functions. In order to maintain bone function, good biocompatibility and a moderate degradation rate are required. In fact, at a moderate degradation rate, bone can retain its properties, while a very slow degradation rate can prevent new bone formation. A high degradation rate cause defects at bone site. It was reported earlier that, if the hydrolysis rate is higher during immersion, water molecules adsorbed by the scaffolds and defects are formed [46]. For perfect appetite layer formation, the degradation rate must be less than 2% per day [47]. Here, prepared hematite NPs showed the required rate. The desired dimensions of the scaffolds relied on the implantation site. Thus, the clinical criteria of bone implants necessitate well-dispersed and spherical NPs.
3.7. Antioxidant Study
Iron oxide NPs are being synthesized for bone implantations; therefore, the study of their antioxidants is very important. The activity was carried out at different concentrations of 15, 25, 50, 100, 150, and 200 µg/mL of iron oxide. The free scavenging radical activity (RSA) improved with the concentration of iron oxide NPs, as shown in Figure 11. Eggshell-mediated hematite NPs showed 95% of RSA, which was higher, as reported earlier [48]. Ascorbic acid was used as the control and exhibited 96% antioxidant activity.

Figure 11.
Free scavenging radical activity of eggshell-mediated hematite NPs.
The results demonstrate that the addition of eggshells enhanced the antioxidant activity. The maximum antioxidant activity achieved by Das el al. [19] was 72.73%, with 800 g/mL concentration of NPs. FTIR spectra showed that the presence of polyphenols groups worked as beneficial antioxidants [49,50]. It was also observed that, during synthesis, iron and polyphenols were formed excessively, and they acted as antioxidant agents by transporting one electron and a hydrogen atom [51,52]. The literature also suggests that additional bioactive compounds may coat spherical NPs, enhancing antioxidant activity [53,54]. The same behavior was observed by Bedlovičová et al. [55] for green synthesized NPs. Thus, hematite NPs scavenge free radicals either by donating electrons or by transferring hydrogen atoms to DPPH radicals. Consequently, they can cease the oxidation process and stop oxidative damage to carbohydrates, proteins, lipids, and nucleic acids [56]. Thus, hematite NPs can be promising agents against cancer and many other diseases in the future due to their potential antioxidant activity.
3.8. In Vitro Bio-Mineralization Study
In vitro bio-mineralization activity was also assessed to check the deposition of minerals such as hydroxyapatite. For this, spherical NPs synthesized by 5 g eggshell-mediated hematite were immersed in stimulated body fluid (SBF) for different time intervals. After 1 week of immersion, the deposition of hydroxyapatite was observed, but the mineralization was less (Figure 12a). Significant bone formation was observed after 5 weeks of mineralization (Figure 12c). After 5 weeks, all pores were filled with minerals and deposited over the surface of the scaffold. The SEM images revealed that mineral deposition increased with the deposition time [57,58].

Figure 12.
SEM images after mineralization of hematite NPs at (a) 1 week, (b) 3 weeks, and (c) 5 weeks.
The literature on in vitro mineralization shows that concentrations of calcium and phosphorus form apatite layers on the surfaces of NPs [59,60]. Calcium and phosphorous are extracted using eggshells, which aid in forming an appetite layer. The thickness of the appetite layer increases as the time increases, and flakes like macromolecules with dimensions of 0.1 cm to 1 cm are noticed. SEM images have shown that mineral deposition increases as the deposition time increases. The appetite layers formed on the surfaces of iron oxide NPs are a sign of good activity. Eggshells and membranes added to NPs have gained potential interest in scaffold and tissue engineering. The presence of eggshells and membranes increases the interaction between the cell and the scaffold. Eggshells and membranes also provide constituent elements, which are necessary for bone regeneration. As compared to previously used materials for scaffolds, such as collagen, they lead to rapid absorption and low hardness, along with low costs. On the other hand, microparticles of additives may increase the sizes of NPs [61], and membranes, as porous materials, may increase the porosity of the scaffolds, as observed in Figure 12.
3.9. Antibacterial Activity
Bone disorders are mainly caused by different infections due to by bacteria. Along with hardness and good mineralizers, scaffolds should have antibiotic properties. Antibiotic properties of nanomaterials make them more useful for medical science. The antibacterial activity of hematite prepared with eggshell extract was tested against the S. aureus and E. Coli bacterial strains. These sol–gel-synthesized materials showed a stronger antibacterial effect, inhibiting the growth of the S. aureus and E. Coli bacterial strains up to 29 mm and 23 mm, respectively (Figure 13a,b). The antibacterial results revealed that iron oxide with eggshells showed very good antibacterial activity by destroying bacterial cells. In fact, the antibacterial activity depended upon the oxidative radicals. Materials synthesized by organic additives have a large number of oxidative radicals, which are responsible for cell damage.
Figure 13.
(a) Antibacterial activity of eggshell-mediated hematite NPs against (a) S. aureus and (b) E. Coli.
Mohamed et al. [62] prepared iron oxide NPs and studied their antibacterial potential against gram-positive and gram-negative bacteria. The antibacterial activity of NPs could be attributed to their large surface area to volume ratio (small size), which was shown by TEM. Hence, this makes their penetration through the cell membrane easy and disturbs the permeability of the cell membrane [63]. Sidkey et al. [64] prepared iron oxide NPs and studied their effects against Aspergillus flavus, with similar results. Hence, iron oxide NPs make direct contact with the surfaces of bacterial cells, which alters the membrane’s permeability. Additionally, the production of ROS causes the destruction of DNA and protein in bacteria, i.e., cell death. Thus, the application of hematite is an alternate therapy to resolve the bacterial resistance against different pathogens.
Antibacterial Mechanism of Hematite NPs
Several studies have proven that hematite NPs are well-known antimicrobial agents against a range of susceptible bacteria and fungi, and are comparable with other materials [65,66].
α-Fe2O3 acts as a double-edged sword, and is capable of damaging proteins, DNA, and lipids via the Fenton reaction [67]. This reaction takes place between Fe2+ ions and hydrogen peroxide (H2O2), which results in the formation of Fe3+ ions and hydroxyl radicals. Further, Fe3+ ions and superoxide radicals (O2−) react to form oxygen molecules (O2) and regenerate Fe2+ ions (initial catalyst). Moreover, another main antibacterial mechanism of hematite NPs is the generation of ROS (reactive oxygen species), which have the ability to damage DNA molecules [68], such as through photocatalysis and Fenton reactions [69]. Metal ions have the potential to bind with carboxyl (–COOH), amino (–NH), and groups of proteins to inactivate or inhibit their functions partially or completely [70]. Moreover, α-Fe2O3 NPs can damage the cell walls of bacteria by direct contact with the cell wall [71]. Also, they can pierce into the cytoplasm, resulting in vacuole formation and cell wall destruction [72].
α-Fe2O3 NPs can also upset the F0/F1-ATPase function and cause a decrease in the flow rate of H+ ions through the membrane, as well as the redox potential [73]. The literature shows that neutral and positively charged iron oxide NPs facilitate a greater reduction in Streptococcus mutans biofilms as compared to negatively charged iron oxide NPs [74]. Iron oxide NPs exhibit the potential for adsorption and penetration into the bacterial cell due to their attractive properties, including hydrophobicity, surface charge, and high surface-to-volume ratio. All of the aforementioned factors result in the bacterial cell’s dissociation and death [75,76]. Figure 14 illustrates the antibacterial mechanism. IONP is gradually gaining recognition as antibacterial agent. However; when compare to other metal oxide and metallic nanoparticles, the bactericidal properties of IONPs are relatively lesser. For example, the inhibitory actions of IONPs are often less pronounced than those of other metal oxides, such as CuO or ZnO [77]. Despite the ambiguous antibacterial potential of IONPs, significant studies have revealed the antibacterial activities of IONPs, which mostly depend on various factors, including the type of microbial strain. Still, IONPs have magnetic and paramagnetic properties which allow for the use of an alternating magnetic field, facilitating the enhancement of the bactericidal action of Fe3O4 NPs against several strains, including E. coli and S. aureus [78].

Figure 14.
Schematic representation of antibacterial Mechanism of hematite NPs [79].
4. Conclusions
Herein, we have demonstrated the preparation of phase-pure hematite (α-Fe2O3) nanoparticles (NPs) using collagen protein and calcium carbonate extracted from eggshell membranes and eggshells, respectively, as organic additives. To study the effect of additives on the quality of the resulting materials, spherical hematite NPs were prepared by the addition of different eggshell contents. The XRD results revealed the formation of a hematite phase, which was found to be reinforced due to the eggshell content. FTIR and RAMAN results further confirmed the phase purity and presence of polyphenols as stabilizing agents, which have contributed to the antioxidant properties of the IONPs. FE-SEM images illustrated the presence of spherical, non-agglomerated NPs with sizes ranging from 40 to 50 nm. Phase purity and stability resulted in high values of hardness and fracture toughness, which are suitable for bone implantation. In vitro biodegradation in PBS led to slight decreases in weight and hardness after 72 h of immersion. Hematite NPs showed 95% radical scavenging activity (RSA) and were good carriers against S. aureus bacteria. A mineralization study of hematite NPs showed the formation of new bone, which was confirmed by SEM images. The thickness of the appetite layer increased as the time increased, and flakes like macromolecules with dimensions of 0.1 cm to 1 cm were observed. Therefore, this study has demonstrated the biological potential of IONPs, which can be useful for various purposes.
Author Contributions
Conceptualization, M.B. and M.K. (Mujeeb Khan); methodology, M.A.; software, F.M., A.S., M.K. (Mufsir Kuniyil) and B.S.; validation, F.M., R.S., B.S.K. and A.S.; formal analysis, M.R.S., M.K. (Mufsir Kuniyil) and B.S.; investigation, M.A.; resources, M.B. and M.K. (Mujeeb Khan); data curation, F.M., R.S., B.S.K. and M.R.S.; writing—original draft preparation, M.A., M.B. and M.K. (Mujeeb Khan); writing—review and editing, M.B., M.K. (Mujeeb Khan) and M.R.S.; visualization, M.B.; supervision, M.B.; project administration, M.B.; funding acquisition, M.R.S. All authors have read and agreed to the published version of the manuscript.
Funding
The authors acknowledge the funding from Researchers Supporting Project number (RSPD2023R665), King Saud University, Riyadh, Saudi Arabia.
Institutional Review Board Statement
Not applicable.
Informed Consent Statement
Not applicable.
Data Availability Statement
Data are contained within the article.
Acknowledgments
The authors acknowledge the funding from Researchers Supporting Project number (RSPD2023R665), King Saud University, Riyadh, Saudi Arabia.
Conflicts of Interest
The authors declare no conflict of interest.
References
- Ali:, A.; Zafar, H.; Zia, M.; ul Haq, I.; Phull, A.R.; Ali, J.S.; Hussain, A. Synthesis, characterization, applications, and challenges of iron oxide nanoparticles. Nanotechnol. Sci. Appl. 2016, 2016, 49–67. [Google Scholar] [CrossRef] [PubMed]
- Kanagasubbulakshmi, S.; Kadirvelu, K. Green synthesis of iron oxide nanoparticles using Lagenaria siceraria and evaluation of its antimicrobial activity. Def. Life Sci. J. 2017, 2, 422–427. [Google Scholar] [CrossRef]
- Chavali, M.S.; Nikolova, M.P. Metal oxide nanoparticles and their applications in nanotechnology. SN Appl. Sci. 2019, 1, 607. [Google Scholar] [CrossRef]
- Thai, T.M.N.; Kim, S.-R.; Kim, H.-J. Synthesis Fe2O3 polymorph thin films via a pulsed laser deposition. Tech. New Phys. Sae Mulli 2014, 64, 252–255. [Google Scholar] [CrossRef]
- Naz, S.; Islam, M.; Tabassum, S.; Fernandes, N.F.; de Blanco, E.J.C.; Zia, M. Green synthesis of hematite (α-Fe2O3) nanoparticles using Rhus punjabensis extract and their biomedical prospect in pathogenic diseases and cancer. J. Mol. Struct. 2019, 1185, 1–7. [Google Scholar] [CrossRef]
- Ennas, G.; Musinu, A.; Piccaluga, G.; Zedda, D.; Gatteschi, D.; Sangregorio, C.; Stanger, J.; Concas, G.; Spano, G. Characterization of iron oxide nanoparticles in an Fe2O3−SiO2 composite prepared by a sol−gel method. Chem. Mater. 1998, 10, 495–502. [Google Scholar] [CrossRef]
- Ahmmad, B.; Leonard, K.; Islam, M.S.; Kurawaki, J.; Muruganandham, M.; Ohkubo, T.; Kuroda, Y. Green synthesis of mesoporous hematite (α-Fe2O3) nanoparticles and their photocatalytic activity. Adv. Powder Technol. 2013, 24, 160–167. [Google Scholar] [CrossRef]
- Kong, H.; Kim, H.; Hwang, S.; Mun, J.; Yeo, J. Laser-induced hydrothermal growth of iron oxide nanoparticles on diverse substrates for flexible micro-supercapacitors. ACS Appl. Nano Mater. 2022, 5, 4102–4111. [Google Scholar] [CrossRef]
- Khanam, J.; Ahmed, M.; Zaman, S.; Sharmin, N.; Ahmed, S. Synthesis of nano-sized magnetic iron oxide by a simple and facile co-precipitation method. Bangladesh J. Sci. Ind. Res. 2022, 57, 67–76. [Google Scholar] [CrossRef]
- Bashir, M.; Riaz, S.; Kayani, Z.; Naseem, S. Synthesis of bone implant substitutes using organic additive based zirconia nanoparticles and their biodegradation study. J. Mech. Behav. Biomed. Mater. 2018, 88, 48–57. [Google Scholar] [CrossRef]
- Rufus, A.; Sreeju, N.; Vilas, V.; Philip, D. Biosynthesis of hematite (α-Fe2O3) nanostructures: Size effects on applications in thermal conductivity, catalysis, and antibacterial activity. J. Mol. Liq. 2017, 242, 537–549. [Google Scholar] [CrossRef]
- Salimikia, I.; Heidari, F. Therapeutic potentials of reserpine formulations:Recent progress and challenges. Micro Nano Bio Asp. 2023, 2, 1–5. [Google Scholar]
- Haddad, B.; Mittal, A.; Mittal, J.; Paolone, A.; Villemin, D.; Debdab, M.; Mimanne, G.; Habibi, A.; Hamidi, Z.; Boumediene, M. Synthesis and characterization of Egg shell (ES) and Egg shell with membrane (ESM) modified by ionic liquids. Chem. Data Collect. 2021, 33, 100717. [Google Scholar] [CrossRef]
- Kim, D.; Gwon, Y.; Park, S.; Kim, W.; Yun, K.; Kim, J. Eggshell membrane as a bioactive agent in polymeric nanotopographic scaffolds for enhanced bone regeneration. Biotechnol. Bioeng. 2021, 118, 1862–1875. [Google Scholar] [CrossRef] [PubMed]
- Pallela, P.N.V.K.; Ummey, S.; Ruddaraju, L.K.; Gadi, S.; Cherukuri, C.S.; Barla, S.; Pammi, S. Antibacterial efficacy of green synthesized α-Fe2O3 nanoparticles using Sida cordifolia plant extract. Heliyon 2019, 5, e02765. [Google Scholar] [CrossRef] [PubMed]
- Buarki, F.; AbuHassan, H.; Al Hannan, F.; Henari, F. Green Synthesis of Iron Oxide Nanoparticles Using Hibiscus rosa sinensis Flowers and Their Antibacterial Activity. J. Nanotechnol. 2022, 2022, 5474645. [Google Scholar] [CrossRef]
- Yoonus, J.; Resmi, R.; Beena, B. Evaluation of antibacterial and anticancer activity of green synthesized iron oxide (α-Fe2O3) nanoparticles. Mater. Today Proc. 2021, 46, 2969–2974. [Google Scholar] [CrossRef]
- Weldegebrieal, G.K.; Sibhatu, A.K. Photocatalytic activity of biosynthesized α-Fe2O3 nanoparticles for the degradation of methylene blue and methyl orange dyes. Optik 2021, 241, 167226. [Google Scholar] [CrossRef]
- Das, D.; Ali, S.; Rajbanshi, B.; Ray, S.; Barman, S.; Chouhan, D.; Haydar, S.; Mandal, P.; Roy, K.; Roy, M. Investigation of Synthesis of Biogenic Hematite Nanocubes for Environmental Assessment and Its Innovative Applications Associated with Antibacterial, Antifungal, and Antioxidant Activity. 2022. Available online: https://doi.org/10.21203/rs.3.rs-1584298/v1 (accessed on 21 November 2023).
- Alturki, A.M.; Alatawi, A.S.; Abulyazied, D.E.; Abomostafa, H.; Alamlah, R.; Taha, M.A.; Youness, R.A. Magnetic and Dielectric Properties of Hybrid Nanocomposites of Biologically Extracted Hydroxyapatite/Hematite/Silicon Dioxide for Potential Use in Bone Replacement Applications. ECS J. Solid State Sci. Technol. 2023, 12, 083001. [Google Scholar] [CrossRef]
- Cree, D.; Rutter, A. Sustainable bio-inspired limestone eggshell powder for potential industrialized applications. ACS Sustain. Chem. Eng. 2015, 3, 941–949. [Google Scholar] [CrossRef]
- Nikoo, M.; Benjakul, S.; Yasemi, M.; Gavlighi, H.A.; Xu, X. Hydrolysates from rainbow trout (Oncorhynchus mykiss) processing by-product with different pretreatments: Antioxidant activity and their effect on lipid and protein oxidation of raw fish emulsion. LWT 2019, 108, 120–128. [Google Scholar] [CrossRef]
- Costa-Pinto, A.R.; Martins, A.M.; Castelhano-Carlos, M.J.; Correlo, V.M.; Sol, P.C.; Longatto-Filho, A.; Battacharya, M.; Reis, R.L.; Neves, N.M. In vitro degradation and in vivo biocompatibility of chitosan–poly (butylene succinate) fiber mesh scaffolds. J. Bioact. Compat. Polym. 2014, 29, 137–151. [Google Scholar] [CrossRef]
- Lončarević, A.; Ivanković, M.; Rogina, A. Lysozyme-induced degradation of chitosan: The characterisation of degraded chitosan scaffolds. J. Tissue Repair Regen. 2017, 1, 12–22. [Google Scholar] [CrossRef]
- Yoshioka, T.; Kawazoe, N.; Tateishi, T.; Chen, G. In vitro evaluation of biodegradation of poly (lactic-co-glycolic acid) sponges. Biomaterials 2008, 29, 3438–3443. [Google Scholar] [CrossRef]
- Kumar, S.; Nehra, M.; Kedia, D.; Dilbaghi, N.; Tankeshwar, K.; Kim, K.-H. Nanotechnology-based biomaterials for orthopaedic applications: Recent advances and future prospects. Mater. Sci. Eng. C 2020, 106, 110154. [Google Scholar] [CrossRef]
- Goujon, G.; Baldim, V.; Roques, C.; Bia, N.; Seguin, J.; Palmier, B.; Graillot, A.; Loubat, C.; Mignet, N.; Margaill, I. Antioxidant activity and toxicity study of cerium oxide nanoparticles stabilized with innovative functional copolymers. Adv. Healthc. Mater. 2021, 10, 2100059. [Google Scholar] [CrossRef]
- Zuo, Q.; Yao, J.; Lu, S.; Du, Z.; Li, S.; Lin, F.; Shi, W.; Zhang, Y.; Xiao, Y. The role of organic phosphate in the spatial control of periodontium complex bio-mineralization: An in vitro study. J. Mater. Chem. B 2019, 7, 5956–5965. [Google Scholar] [CrossRef]
- Ma, X.; Li, D.; Jin, H.; Zeng, X.; Qi, J.; Yang, Z.; You, F.; Yuan, F. Urchin-like band-matched Fe2O3@ In2S3 hybrid as an efficient photocatalyst for CO2 reduction. J. Colloid Interface Sci. 2023, 648, 1025–1033. [Google Scholar] [CrossRef]
- Chen, M.; Pei, Z.; Wang, X.; Sun, C.; Wen, L. Structural, electrical, and optical properties of transparent conductive oxide ZnO: Al films prepared by dc magnetron reactive sputtering. J. Vac. Sci. Technol. A Vac. Surf. Film. 2001, 19, 963–970. [Google Scholar] [CrossRef]
- Cullity, B.D. Elements of X-ray Diffraction; Addison-Wesley Publishing: Boston, MA, USA, 1956. [Google Scholar]
- Gailer, J.; Turner, R.J. Environmental and Biochemical Toxicology: Concepts, Case Studies and Challenges; Walter de Gruyter GmbH & Co KG: Berlin, Germany, 2022. [Google Scholar]
- Jubb, A.M.; Allen, H.C. Vibrational spectroscopic characterization of hematite, maghemite, and magnetite thin films produced by vapor deposition. ACS Appl. Mater. Interfaces 2010, 2, 2804–2812. [Google Scholar] [CrossRef]
- Zhang, Y.; Cui, W.; An, W.; Liu, L.; Liang, Y.; Zhu, Y. Combination of photoelectrocatalysis and adsorption for removal of bisphenol A over TiO2-graphene hydrogel with 3D network structure. Appl. Catal. B Environ. 2018, 221, 36–46. [Google Scholar] [CrossRef]
- Bersani, D.; Lottici, P.; Montenero, A. Micro-Raman investigation of iron oxide films and powders produced by sol–gel syntheses. J. Raman Spectrosc. 1999, 30, 355–360. [Google Scholar] [CrossRef]
- Yang, H.; Wu, Q.; Li, J.; Dai, W.; Zhang, H.; Lu, D.; Gao, S.; You, W. Direct synthesis of phenol from benzene catalyzed by multi-V-POMs complex. Appl. Catal. A 2013, 457, 21–25. [Google Scholar] [CrossRef]
- Majid, F.; Bashir, M.; Bibi, I.; Raza, A.; Ezzine, S.; Alwadai, N.; Iqbal, M. ZnO nanofibers fabrication by hydrothermal route and effect of reaction time on dielectric, structural and optical properties. J. Mater. Sci. Technol. 2022, 18, 4019–4029. [Google Scholar] [CrossRef]
- Mansur, H.S.; Sadahira, C.M.; Souza, A.N.; Mansur, A.A. FTIR spectroscopy characterization of poly (vinyl alcohol) hydrogel with different hydrolysis degree and chemically crosslinked with glutaraldehyde. Mater. Sci. Eng., C 2008, 28, 539–548. [Google Scholar] [CrossRef]
- Yang, T.H.; Shi, Y.; Janssen, A.; Xia, Y. Surface capping agents and their roles in shape-controlled synthesis of colloidal metal nanocrystals. Angew. Chem. Int. Ed. 2020, 59, 15378–15401. [Google Scholar] [CrossRef]
- JIS R-1607; Testing Method for Fracture Toughness of High Performance Ceramics. Japanese Standards Association (JSA): Tokyo, Japan, 1990.
- Jenkins, R.; Snyder, R.L. Introduction to X-ray Powder Diffractometry; Wiley Online Library: Hoboken, NJ, USA, 1996; Volume 138. [Google Scholar]
- Moradkhani, A.; Baharvandi, H.; Tajdari, M.; Latifi, H.; Martikainen, J. Determination of fracture toughness using the area of micro-crack tracks left in brittle materials by Vickers indentation test. J. Adv. Ceram. 2013, 2, 87–102. [Google Scholar] [CrossRef]
- Ponton, C.B.; Rawlings, R.D. Vickers indentation fracture toughness test Part 1 Review of literature and formulation of standardised indentation toughness equations. Mater. Sci. Technol. 1989, 5, 865–872. [Google Scholar] [CrossRef]
- Niihara, K.; Morena, R.; Hasselman, D. Evaluation of K Ic of brittle solids by the indentation method with low crack-to-indent ratios. J. Mater. Sci. Lett. 1982, 1, 13–16. [Google Scholar] [CrossRef]
- Betova, I.; Bojinov, M.; Saario, T. Film-Forming Amines in Steam/Water Cycles–structure, properties, and influence on corrosion and deposition processes. In Research Report VTT-R-03234-14; VTT: Espoo, Finland, 2014. [Google Scholar]
- Sousa, R.; Lobato, J.; Maurício, A.; Hussain, N.; Botelho, C.; Lopes, M.; Santos, J. A clinical report of bone regeneration in maxillofacial surgery using Bonelike® synthetic bone graft. J. Biomater. Appl. 2008, 22, 373–385. [Google Scholar] [CrossRef]
- Zeng, J.; Guo, J.; Sun, Z.; Deng, F.; Ning, C.; Xie, Y. Osteoblastic and anti-osteoclastic activities of strontium-substituted silicocarnotite ceramics: In vitro and in vivo studies. Bioact. Mater. 2020, 5, 435–446. [Google Scholar] [CrossRef] [PubMed]
- Alshawwa, S.Z.; Mohammed, E.J.; Hashim, N.; Sharaf, M.; Selim, S.; Alhuthali, H.M.; Alzahrani, H.A.; Mekky, A.E.; Elharrif, M.G. In Situ biosynthesis of reduced alpha hematite (α-Fe2O3) nanoparticles by Stevia Rebaudiana L. leaf extract: Insights into antioxidant, antimicrobial, and anticancer properties. Antibiotics 2022, 11, 1252. [Google Scholar] [CrossRef] [PubMed]
- Song, S.; Liu, X.; Huang, J.; Zhang, Z. Neural stem cell-laden 3D bioprinting of polyphenol-doped electroconductive hydrogel scaffolds for enhanced neuronal differentiation. Biomater. Adv. 2022, 133, 112639. [Google Scholar] [CrossRef] [PubMed]
- Gao, X.; Xu, Z.; Liu, G.; Wu, J. Polyphenols as a versatile component in tissue engineering. Acta Biomater. 2021, 119, 57–74. [Google Scholar] [CrossRef]
- Bhattarai, G.; Jeon, Y.-M.; Choi, K.-C.; Wagle, S.; Sim, H.-J.; Kim, J.-I.; Zhao, S.; Kim, J.-G.; Cho, E.-S.; Kook, S.-H. Functional improvement of collagen-based bioscaffold to enhance periodontal-defect healing via combination with dietary antioxidant and COMP-angiopoietin 1. Biomater. Adv. 2022, 135, 112673. [Google Scholar] [CrossRef]
- Taresco, V.; Crisante, F.; Francolini, I.; Martinelli, A.; D’Ilario, L.; Ricci-Vitiani, L.; Buccarelli, M.; Pietrelli, L.; Piozzi, A. Antimicrobial and antioxidant amphiphilic random copolymers to address medical device-centered infections. Acta Biomater. 2015, 22, 131–140. [Google Scholar] [CrossRef]
- Couto, D.S.; Hong, Z.; Mano, J.F. Development of bioactive and biodegradable chitosan-based injectable systems containing bioactive glass nanoparticles. Acta Biomater. 2009, 5, 115–123. [Google Scholar] [CrossRef]
- Küp, F.Ö.; Çoşkunçay, S.; Duman, F. Biosynthesis of silver nanoparticles using leaf extract of Aesculus hippocastanum (horse chestnut): Evaluation of their antibacterial, antioxidant and drug release system activities. Mater. Sci. Eng. C 2020, 107, 110207. [Google Scholar] [CrossRef]
- Bedlovičová, Z.; Strapáč, I.; Baláž, M.; Salayová, A. A brief overview on antioxidant activity determination of silver nanoparticles. Molecules 2020, 25, 3191. [Google Scholar] [CrossRef]
- Zakariya, N.A.; Majeed, S.; Jusof, W.H.W. Investigation of antioxidant and antibacterial activity of iron oxide nanoparticles (IONPS) synthesized from the aqueous extract of Penicillium spp. Sens. Int. 2022, 3, 100164. [Google Scholar] [CrossRef]
- Liu, F.; Hu, K.; Al-Qudsy, L.H.; Wu, L.-Q.; Wang, Z.; Xu, H.-Y.; Yang, H.; Yang, P.-F. Aging exacerbates the morphological and mechanical response of mineralized collagen fibrils in murine cortical bone to disuse. Acta Biomater. 2022, 152, 345–354. [Google Scholar] [CrossRef] [PubMed]
- Diogo, G.S.; Marques, C.F.; Freitas-Ribeiro, S.; Sotelo, C.G.; Pérez-Martin, R.I.; Pirraco, R.P.; Reis, R.L.; Silva, T.H. Mineralized collagen as a bioactive ink to support encapsulation of human adipose stem cells: A step towards the future of bone regeneration. Biomater. Adv. 2022, 133, 112600. [Google Scholar] [CrossRef] [PubMed]
- Teimouri, A.; Ebrahimi, R.; Emadi, R.; Beni, B.H.; Chermahini, A.N. Nano-composite of silk fibroin–chitosan/Nano ZrO2 for tissue engineering applications: Fabrication and morphology. Int. J. Biol. Macromol. 2015, 76, 292–302. [Google Scholar] [CrossRef] [PubMed]
- Rasheed, T.; Bilal, M.; Zhao, Y.; Raza, A.; Shah, S.Z.H.; Iqbal, H.M. Physiochemical characteristics and bone/cartilage tissue engineering potentialities of protein-based macromolecules—A review. Int. J. Biol. Macromol. 2019, 121, 13–22. [Google Scholar] [CrossRef] [PubMed]
- Javid, H.; Ahmadi, S.; Mohamadian, E. Therapeutic applications of apigenin and its derivatives: Micro and nano aspects. Micro Nano Bio Asp. 2023, 2, 30–38. [Google Scholar]
- Mohamed, Y.; Azzam, A.; Amin, B.; Safwat, N. Mycosynthesis of iron nanoparticles by Alternaria alternata and its antibacterial activity. Afr. J. Biotechnol. 2015, 14, 1234–1241. [Google Scholar] [CrossRef]
- Suba, S.; Vijayakumar, S.; Vidhya, E.; Punitha, V.; Nilavukkarasi, M. Microbial mediated synthesis of ZnO nanoparticles derived from Lactobacillus spp: Characterizations, antimicrobial and biocompatibility efficiencies. Sens. Int. 2021, 2, 100104. [Google Scholar] [CrossRef]
- Sidkey, N. Biosynthesis, characterization and antimicrobial activity of iron oxide nanoparticles synthesized by fungi. Al-Azhar J. Pharm. Sci. 2020, 62, 164–179. [Google Scholar] [CrossRef]
- Gudkov, S.V.; Burmistrov, D.E.; Serov, D.A.; Rebezov, M.B.; Semenova, A.A.; Lisitsyn, A.B. A mini review of antibacterial properties of ZnO nanoparticles. Front. Phys. 2021, 9, 641481. [Google Scholar] [CrossRef]
- Alavi, M.; Kowalski, R.; Capasso, R.; Douglas Melo Coutinho, H.; Rose Alencar de Menezes, I. Various novel strategies for functionalization of gold and silver nanoparticles to hinder drug-resistant bacteria and cancer cells. Micro Nano Bio Asp. 2022, 1, 38–48. [Google Scholar] [CrossRef]
- Fenton, H.J.H. LXXIII.—Oxidation of tartaric acid in presence of iron. J. Chem. Soc. Trans. 1894, 65, 899–910. [Google Scholar] [CrossRef]
- AlMatar, M.; Makky, E.A.; Var, I.; Koksal, F. The role of nanoparticles in the inhibition of multidrug-resistant bacteria and biofilms. Curr. Drug Deliv. 2018, 15, 470–484. [Google Scholar] [CrossRef] [PubMed]
- Groiss, S.; Selvaraj, R.; Varadavenkatesan, T.; Vinayagam, R. Structural characterization, antibacterial and catalytic effect of iron oxide nanoparticles synthesised using the leaf extract of Cynometra ramiflora. J. Mol. Struct. 2017, 1128, 572–578. [Google Scholar] [CrossRef]
- Kazimierczak, P.; Golus, J.; Kolmas, J.; Wojcik, M.; Kolodynska, D.; Przekora, A. Noncytotoxic zinc-doped nanohydroxyapatite-based bone scaffolds with strong bactericidal, bacteriostatic, and antibiofilm activity. Biomater. Adv. 2022, 139, 213011. [Google Scholar] [CrossRef] [PubMed]
- Sousa, C.; Sequeira, D.; Kolen’ko, Y.V.; Pinto, I.M.; Petrovykh, D.Y. Analytical protocols for separation and electron microscopy of nanoparticles interacting with bacterial cells. Anal. Chem. 2015, 87, 4641–4648. [Google Scholar] [CrossRef] [PubMed]
- Li, Y.; Yang, D.; Wang, S.; Li, C.; Xue, B.; Yang, L.; Shen, Z.; Jin, M.; Wang, J.; Qiu, Z. The detailed bactericidal process of ferric oxide nanoparticles on E. coli. Molecules 2018, 23, 606. [Google Scholar] [CrossRef]
- Gabrielyan, L.; Hovhannisyan, A.; Gevorgyan, V.; Ananyan, M.; Trchounian, A. Antibacterial effects of iron oxide (Fe3O4) nanoparticles: Distinguishing concentration-dependent effects with different bacterial cells growth and membrane-associated mechanisms. Appl. Microbiol. Biotechnol. 2019, 103, 2773–2782. [Google Scholar] [CrossRef]
- Javanbakht, T.; Laurent, S.; Stanicki, D.; Wilkinson, K.J. Relating the surface properties of superparamagnetic iron oxide nanoparticles (SPIONs) to their bactericidal effect towards a biofilm of Streptococcus mutans. PLoS ONE 2016, 11, e0154445. [Google Scholar] [CrossRef]
- Li, W.; Wei, W.; Wu, X.; Zhao, Y.; Dai, H. The antibacterial and antibiofilm activities of mesoporous hollow Fe3O4 nanoparticles in an alternating magnetic field. Biomater. Sci. 2020, 8, 4492–4507. [Google Scholar] [CrossRef]
- Alavi, M.; Hamblin, M.R.; Kennedy, J.F. Antimicrobial applications of lichens: Secondary metabolites and green synthesis of silver nanoparticles: A review. Nano Micro Biosyst. 2022, 1, 15–21. [Google Scholar]
- Yu, J.; Zhang, W.; Li, Y.; Wang, G.; Yang, L.; Jin, J.; Chen, Q.; Huang, M. Synthesis, characterization, antimicrobial activity and mechanism of a novel hydroxyapatite whisker/nano zinc oxide biomaterial. Biomed. Mater. 2014, 10, 015001. [Google Scholar] [CrossRef]
- Lee, C.; Kim, J.Y.; Lee, W.I.; Nelson, K.L.; Yoon, J.; Sedlak, D.L. Bactericidal effect of zero-valent iron nanoparticles on Escherichia coli. Environ. Sci. Technol. 2008, 42, 4927–4933. [Google Scholar] [CrossRef]
- Gudkov, S.V.; Burmistrov, D.E.; Serov, D.A.; Rebezov, M.B.; Semenova, A.A.; Lisitsyn, A.B. Do iron oxide nanoparticles have significant antibacterial properties? Antibiotics 2021, 10, 884. [Google Scholar] [CrossRef]
Disclaimer/Publisher’s Note: The statements, opinions and data contained in all publications are solely those of the individual author(s) and contributor(s) and not of MDPI and/or the editor(s). MDPI and/or the editor(s) disclaim responsibility for any injury to people or property resulting from any ideas, methods, instructions or products referred to in the content. |
© 2023 by the authors. Licensee MDPI, Basel, Switzerland. This article is an open access article distributed under the terms and conditions of the Creative Commons Attribution (CC BY) license (https://creativecommons.org/licenses/by/4.0/).














